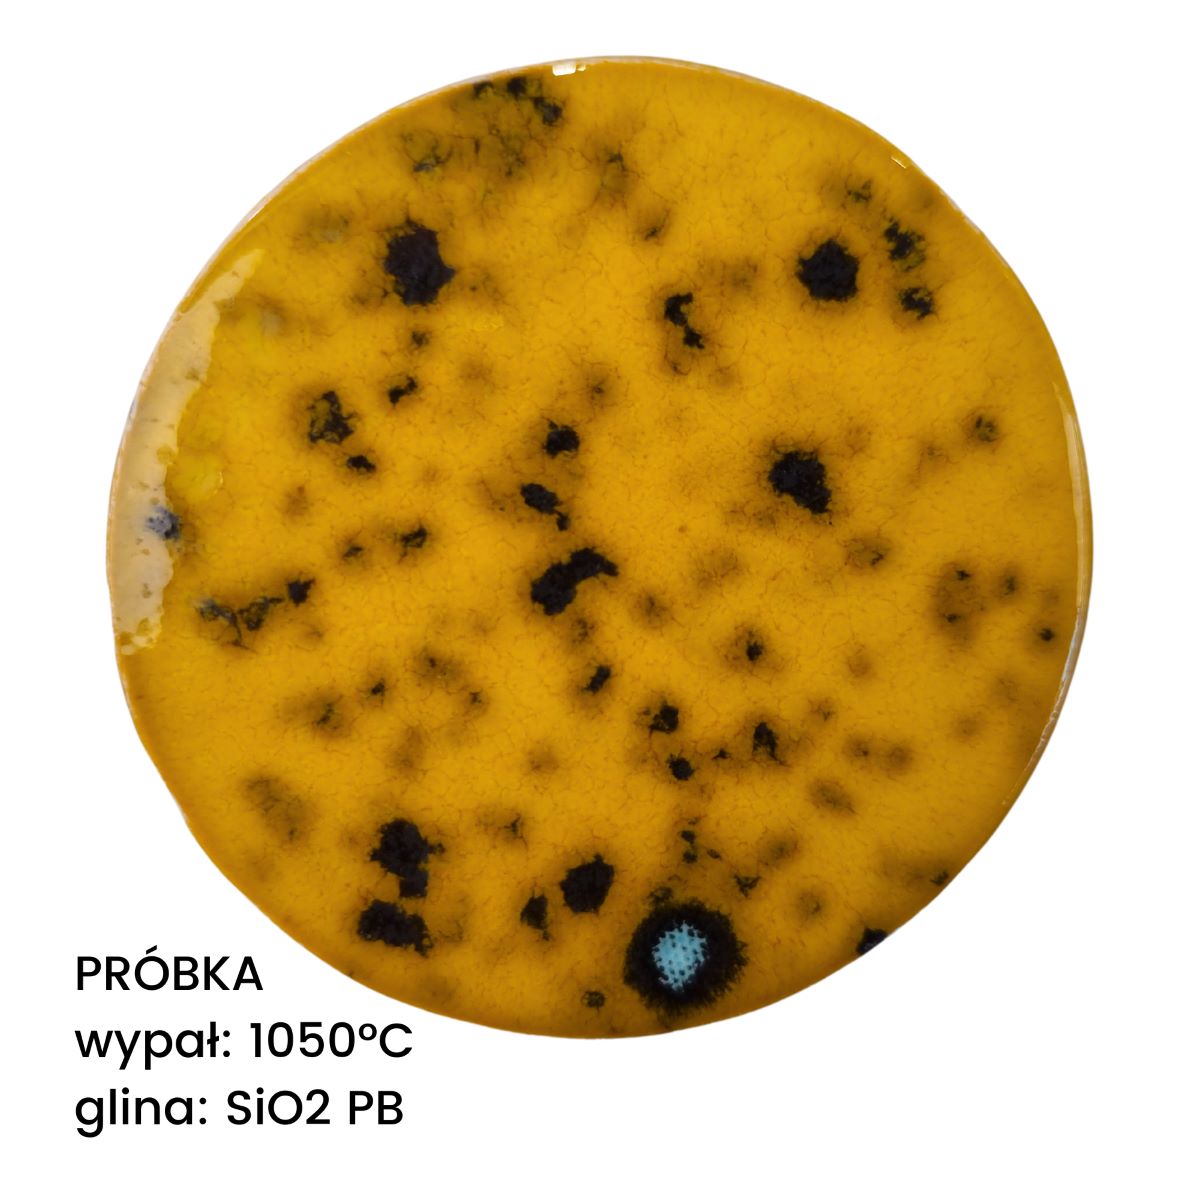

Ceramiq®
Ceramiq Viral Glaze Sun Crater
Ceramiq Viral Glaze Sun Crater
Couldn't load pickup availability
Product description
Product description
Ceramiq Viral Glaze Sunny Crater liquid glaze
- color: yellow with brown spots;
- effect: shiny, covering, effect;
- recommended firing temperature: 1020-1180 °C;
- maximum firing temperature: 1250 °C;
- 250 g package;
Viral Glaze is a series of glazes chosen by our customers - proven, stylish, loved!
How to use:
- Mix well before use.
- Apply 2-3 layers evenly.
- For dipping, pouring or spraying, add 5-10% water.
- Fire within the specified temperature range.
- Test firing recommended.
- Store in an airtight container at room temperature.
Glaze fired at a high temperature may differ from glaze fired at the recommended temperature. These differences may include a change in the shade or color of the glaze.
Some glazes fired above the recommended temperature may "flow".
We encourage you to make your own samples!
We strive to ensure that the glaze samples we provide faithfully reflect the character of the fired material. However, we do not test every batch. Therefore, we cannot guarantee perfect color reproduction.
Differences between the final effect and the presented photos or previously completed works may be caused by differences in individual monitor settings, the firing method or the application of the glaze itself.
We always recommend making your own sample before glazing a large or particularly important batch of material.
Product features
Product features
| efekt_wizualny | Metallic, Multicolored, effective |
|---|---|
| kolor | brown, multicolored, yellow |
| polski_tytul | ceramiq-viral-glaze-sunny-crater |
| polysk | Shiny |
| przezroczystosc | Covering |
| stabilnosc | medium-flowing |
| zakres_temperatur | Low melting 850-1099°C |
| zastosowanie | Artistic forms, Ceramic tiles, Decorations, jewelry |
How to use?
How to use?
Complaints and returns
Complaints and returns
Pursuant to Article 9 of Directive 2011/83/EU of the European Parliament and of the Council on consumer rights, consumers have the right to withdraw from the contract within 14 days. Detailed rules are set out in the Ceramiq.pro Store Terms and Conditions.
Shipping costs
Shipping costs
The cost of packaging and delivery depends on the type and weight of the products ordered.
To find out the price, complete your order and go to the cart page. Below the list of products, you will see a list of available options and a summary of shipping costs.
Standard delivery service does not include carrying in or unpacking the shipment. The maximum weight of 1 order cannot exceed 30 kg (weight with packaging). Orders consisting of products, none of which are heavier than 30 kg, are sent in one package (shipment). If you are interested in purchasing a larger quantity of goods, please place several separate orders.
Some forms of delivery or payment may be unavailable for selected products or countries, due to restrictions introduced by carriers.
Important! If you receive a message that we do not deliver to your country (Europe), make sure that the weight of a single order - 30 kg - has not been exceeded.
Shipping Notice:
For safety reasons, plaster molds are shipped individually. We do not
combine multiple molds in one order, as we cannot guarantee they will
arrive intact. This helps minimize the risk of damage during transport.
Product safety
Product safety
Seller: Ceramiq.pl Sp. z o. o. (formerly: Ceramiq.pl Agnieszka Barnat), KRS 0001144557, NIP: 5214099429, BDO 000663733, 02-908 Warsaw, ul. Czyżewska 5, telephone: +48 222 501 777.
All products available in the Ceramiq.pro store meet safety requirements in accordance with applicable Polish and EU law. We ensure the quality and origin of our materials to ensure they are completely safe both during the creation process and in the finished ceramic products.
- Support and advice
- Easy product return
- Fast home delivery








Ask about the product
Send us your product questions. We'll be happy to provide any information and advise you on your selection. We'll respond as quickly as possible, so you can make an informed decision and enjoy your purchase with confidence.
A wide selection of materials
Everything you need for pottery – clay, glazes, paints, tools and kilns.
Professional advice
Experts are happy to help you choose products and provide practical tips.
Workshops and courses
Develop your skills at the Ceramics School and during inspiring workshops.
Passion and community
A place where ceramists meet, share experiences and support each other.